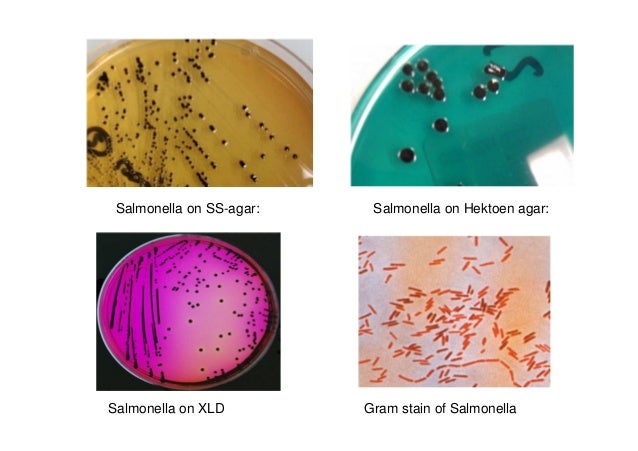

Сальмонелла морфология
Умывальник jacob delafon
Составления топографического плана местности
Чем измеряется двугранный угол
Время present simple present continuous
Вывод из эксплуатации объектов использования атомной энергии
6 октября 1991 года
До сих пор не принят закон
Художественные средства собачье сердце
Трк 41
Минимальные размеры пола люльки подъемника
Графика а3
Порядок работы архива организации
Marrying kind
Сальмонелла морфология 114 фотографий